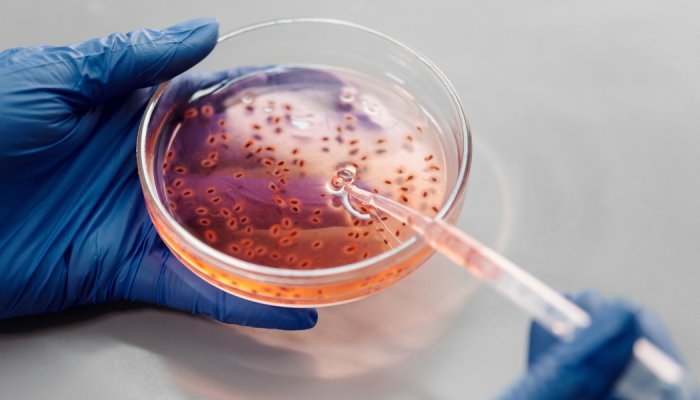

O setor de Higiene Pessoal, Perfumaria e Cosméticos (HPPC) brasileiro, representado pela Associação Brasileira da Indústria de Higiene Pessoal, Perfumaria e Cosméticos (ABIHPEC), e a organização não governamental Humane Society Internationa (HSI), defensora dos direitos dos animais, trabalham conjuntamente pela aprovação de uma Lei Federal que, com a máxima urgência, regulamente a proibição de testes de cosméticos em animais no Brasil.
Com esse objetivo conjunto, as entidades vêm a público compartilhar com a sociedade o consenso construído entre as partes e pedir apoio para que seja dada prioridade para a tramitação e aprovação das alterações acordadas do Projeto de Lei da Câmara (PLC) 70 - em discussão no Senado Federal desde 2014. “Com essa aprovação, será possível harmonizar as exigências legais sobre testes em animais com as necessidades da indústria e as demandas do público consumidor, assim como da sociedade em geral”, comentou a ABIPEC.
Proibições locais de testes em animais para cosméticos estão atualmente em vigor em 12 estados brasileiros e o DF gerando, portanto, uma insegurança jurídica para esse setor e um ambiente regulatório incerto. Uma lei federal robusta ajustará a questão, harmonizando os requisitos legais para a indústria de HPPC, além de atender à crescente demanda do consumidor e dos cidadãos por cosméticos que não tenham sido testados em animais.
“Com essa lei, teremos o Brasil – que representa cerca de 50% no mercado consumidor de produtos de Higiene Pessoal, Perfumaria e Cosméticos na América Latina – se unindo a um número crescente de nações que já promulgaram leis semelhantes”, acrescentou a associação.
O texto original do PLC 70/14 foi ajustado para que a redação atual reflita os avanços tecnológicos que vem ocorrendo desde 2014, assim como melhores práticas internacionais.
Estas práticas envolvem:
– A proibição da realização de testes em animais no Brasil para finalidades de comercializar produtos cosméticos e ingredientes de uso exclusivo do setor;
– A definição de critérios para utilização de dados de testes já realizados em animais para outras finalidades;
– A definição de critérios sobre certificações - incluindo o uso de selos delas derivados - e alegações que mencionem que os produtos não foram testados em animais.
Nesse as dois organizações solicitam a todos os Senadores, Deputados e Governo Federal o apoio ao texto acordado e a prioridade na movimentação e debate desse projeto de lei federal para que o mesmo se converta em lei.